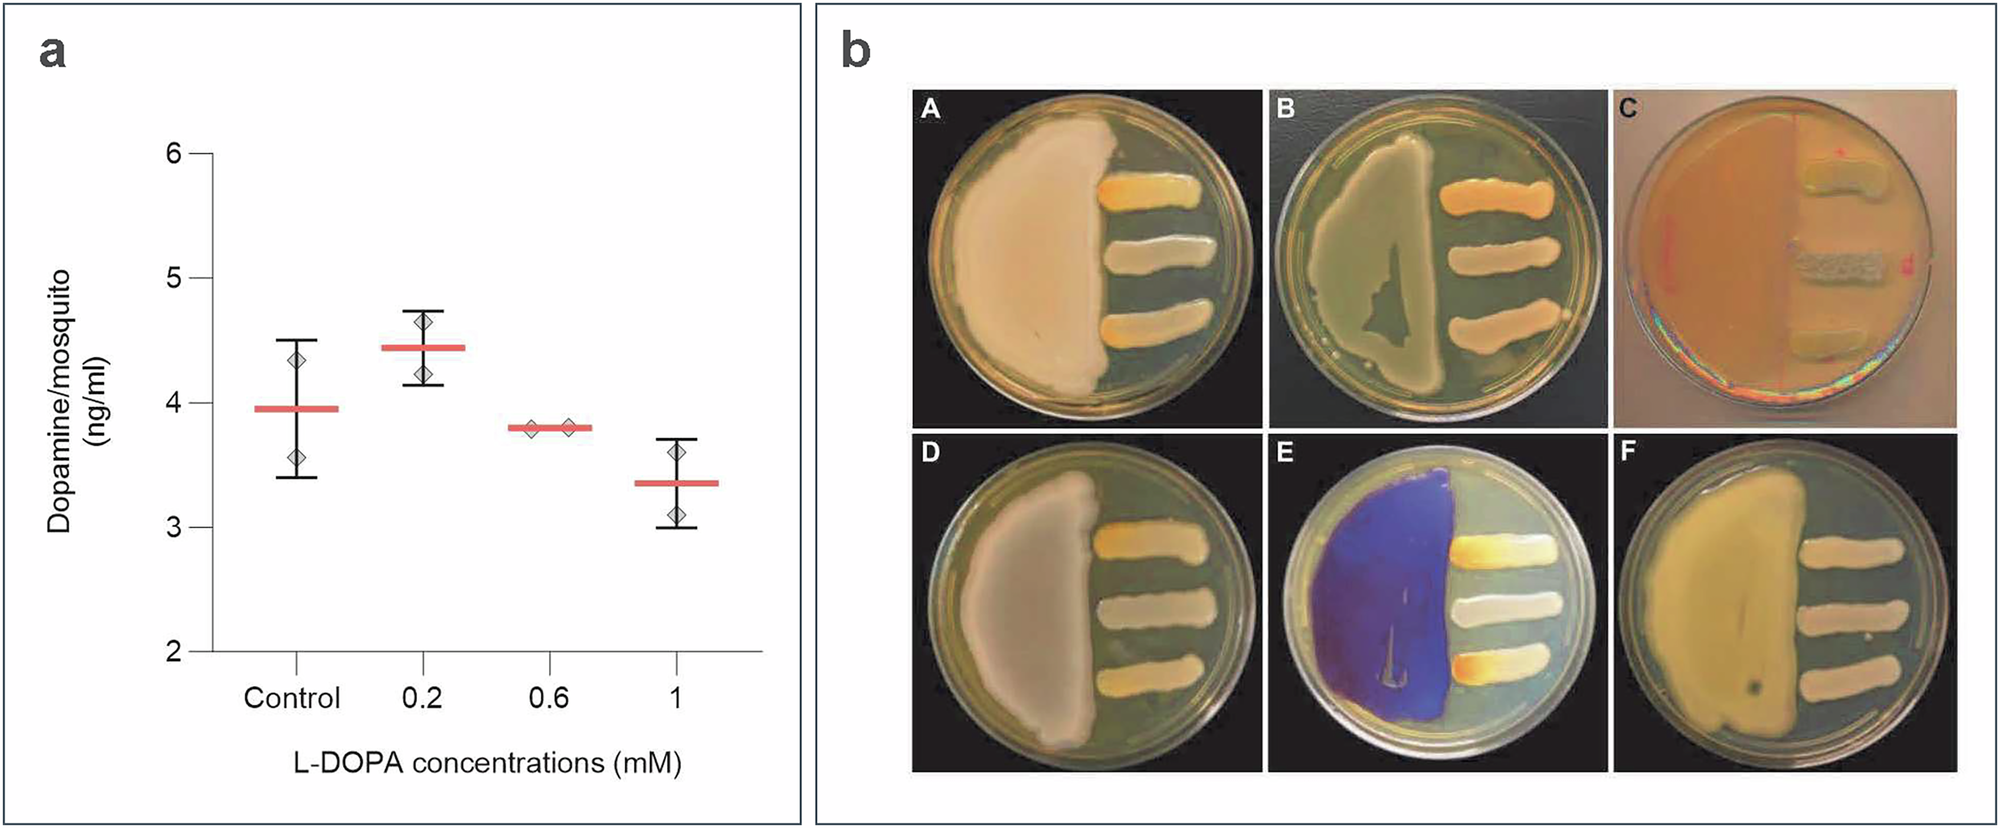
Fig. 9

Fig. 9: Dietary L-DOPA metabolism and probing for dopaminergic bacteria amongst gut microbiota from field-caught mosquitoes.
a Quantification of dopamine by HPLC from whole Anopheles mosquitoes post 4 d of dietary L-DOPA suggests tight regulation of L-DOPA conversion into dopamine. Data correspond to 2 independent biological replicates from 5-pooled mosquitoes per condition. Scatter dot plot with mean and s.d. b Plate confrontational assays showed induced fungal melanization due to melanin precursors released by bacterial isolates. A) Comamonas sp.; B) Enterococcus hormaechei; C) Aeromonas hydrophila; D) Serratia marcescens E) Chromobacterium subtsugae ∆vioS F) Enterococcus sp. Cryptococcus strains (top: C. gattii WM179; middle: C. neoformans lac1∆; bottom: C. neoformans H99) were streaked perpendicular to bacterial isolates in SM plates. The plates were incubated at 30˚C for 5-7 days. Images are representative of 3 biological replicates.
